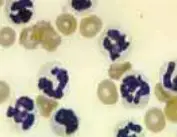
Featured Image

Diagnostic Peritoneal Lavage
Jim Wohl, DVM, Auburn University

Overview
Causes of septic peritonitis include ruptured bowel or infected genitourinary organs; ruptured intraabdominal abscess; introduction of microbes through penetrating wounds; extension of abdominal or retroperitoneal organ infections; postoperative dehiscence associated with gastrointestinal surgery; and contamination with abnormal abdominal effusions, such as bile or urine. Clinical signs in the animal with septic peritonitis vary and depend on the chronicity and extent of inflammation.
Signs of Severe Sepsis
Severe acute inflammation of the peritoneum and circulation of bacterial products and endogenous inflammatory mediators induce the following physiologic responses associated with severe sepsis: fever or subnormal body temperature; tachycardia; irregular respiratory patterns; tachypnea; pale, gray, or red mucous membranes; depressed mental state; and a rapid pulse rate that may be irregular, faint, or bounding.1 Other signs associated with acute abdomen that could be consistent with septic peritonitis include dehydration, abdominal pain, vomiting, diarrhea, and occasionally abdominal distention.2-4 An aggressive diagnostic approach is warranted in animals exhibiting any combination of these clinical signs to determine the cause of the underlying disease and assess whether emergency laparotomy is indicated.
Abdominal effusion may not be evident during physical examination or radiographically in patients with early or localized septic peritonitis.5 Abdominal ultrasonography is more sensitive than radiography for identifying small amounts of intraabdominal fluid.6 In addition, ultrasonographic guidance may be helpful for fine-needle aspiration of small fluid pockets for fluid analysis and cytologic evaluation. Cytologic evaluation is the only means of diagnosing septic peritonitis before surgical intervention. Definitive diagnosis is based on the presence of degenerative neutrophils and intracellular bacteria.2 Other cytologic findings that may be present include degenerative inflammatory cells without intracellular bacteria, extracellular bacteria, and free food particles.
Abdominocentesis or DPL?
Collection of fluid or cytologic samples from the peritoneal cavity is accomplished by abdominocentesis or DPL.5,7,8 Abdominal radiography should be completed before invasive collection of peritoneal fluid as air may enter the peritoneal cavity during collection, and iatrogenic pneumoperitoneum may be mistaken for spontaneous pneumoperitoneum on subsequent radiographs. Neither abdominocentesis nor DPL requires general anesthesia, although sedation and local anesthesia with lidocaine may be required in some animals. Abdominocentesis is an unreliable method of obtaining fluid samples if there is less than 5 to 7 ml/kg of fluid in the peritoneum or when focal disease is present.8 When abdominocentesis fails to withdraw fluid, DPL should be performed.
Step-by-Step: How to Perform Peritoneal Lavage
What You Will Need
Specialized catheters designed for fluid collection
OR
14-gauge, 2.5- to 5.5-inch, over-the-needle catheter (18-gauge, 2-inch catheter for cats and very small dogs)
Sterile scalpel blade or scissors
2 ml 2% lidocaine (without epinephrine)
Urinary catheter
20 ml/kg warm sterile saline
Sterile injection cap
Sterile collection system (preferred) or syringe
Step 1
Clip the ventral midline and cleanse with a disinfectant scrub. Specialized catheters designed for fluid collection through peritoneal lavage are available. Alternatively, you can use a 14-gauge, 2.5- to 5.5-inch, over-the-needle catheter. Making three or four fenestrations at the distal third of the catheter with a sterile scalpel blade or scissors may facilitate drainage of fluid.
Take care to avoid compromising the catheter while creating the fenestrations.

Step 2
After the ventral abdomen is prepared, inject 2 ml of 2% lidocaine (without epinephrine) at the predetermined catheter site, 2 to 3 cm caudal and lateral to the umbilicus. Catheterize and drain the urinary bladder before placement of the abdominal catheter to assist in avoiding inadvertent trauma to the urinary bladder. Make a release incision in the skin.

Step 3
Insert a catheter into the peritoneal cavity and advance it caudodorsally to the region of the urinary bladder.
Catheterize and drain the urinary bladder before placing the abdominal catheter to avoid trauma to the urinary bladder.
Catheterize and drain the urinary bladder before placing the abdominal catheter to avoid trauma to the urinary bladder.

Step 4
When 50% of the catheter has penetrated the peritoneal cavity, advance the catheter off the stylet while simultaneously withdrawing the stylet to minimize puncture of intraabdominal structures.

Step 5
Seat the catheter to the hub.
Step 6
After removing the stylet, infuse 20 ml/kg of warm sterile saline through the catheter.

Step 7
Occlude the catheter with a sterile injection cap and gently roll the patient laterally back and forth to distribute the saline throughout the abdominal cavity.

Step 8
After distributing the fluid, return the patient to lateral recumbency and attach a sterile collection system or syringe to the catheter.

Step 9
Gravity flow through a sterile collection system is preferred, as aspiration by syringe often results in occlusion of the catheter with intraabdominal fat or omentum. Collecting less fluid than the amount infused is common and is not a concern as long as at least 5 to 10 ml is collected for diagnostic sampling.

Peritoneal fluid should always be evaluated cytologically. Biochemical analyses can also be performed, but dilutional effects of the infused fluid must be considered when interpreting results.
Peritoneal fluid should always be evaluated cytologically. If a large amount of fluid is obtained, centrifugation of a small amount will deposit the cellular contents in the bottom of a receptacle. The remaining cellular plug can then be aspirated and prepared on a glass slide for microscopic evaluation after staining with Diff-Quik (Baxter Diagnostics, McGaw Park, IL) or Romanowsky-type stain.
Evaluation of Abdominal Lavage Fluid
Abdominal effusion can result from neoplasia, septic and nonseptic inflammation, hemorrhage, lymphatic obstruction, and ruptured viscous. The hallmark of septic inflammation is the presence of bacteria and degenerative neutrophils on cytologic evaluation. Bacterial culture and sensitivity testing should be performed if septic inflammation is suspected cytologically. Nondegenerative neutrophils and lack of bacteria, as seen with acute pancreatitis, characterize nonseptic inflammation. Other significant cytologic findings include neoplastic cells, bilirubin crystals indicative of biliary tract rupture, and fat droplets and mature lymphocytes in chylous effusions.10
Due to dilutional effects of the infused saline, chemistry values are less reliable in the assessment of uroabdomen (creatinine) and pancreatitis (lipase). While the concentration of bilirubin in fluid will also be diluted, the presence of bilirubin crystals in DPL fluid is still indicative of biliary tract rupture. Pink fluid with a PCV greater than 4% suggests significant intraabdominal hemorrhage. White blood cell counts greater than 1000/mm3 indicate inflammation (by definition, peritonitis) and should be closely examined microscopically for the aforementioned signs of septic peritonitis.11

Peritoneal lavage is performed as a means of detecting septic inflammation and deciding whether a patient needs emergency surgery. Left: Septic inflammation (from a dog with pancreatitis). Note the degenerative neutrophils, particulate matter, and bacteria. Right: Nonseptic inflammation (pancreatitis) characterized by nondegenerative neutrophils and absence of bacteria